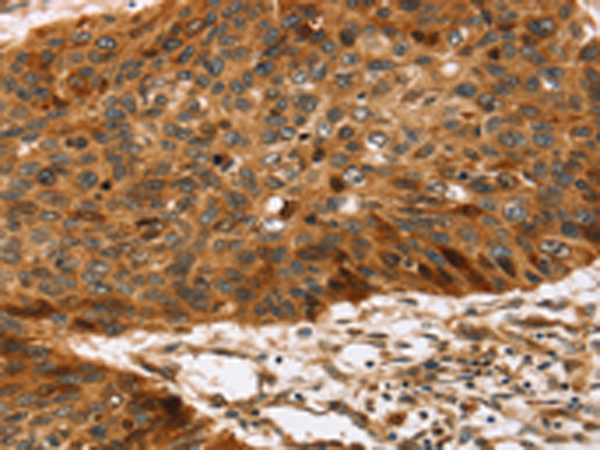
一抗

|
Background: |
The protein encoded by this gene catalyzes the O-sulfation of tyrosine residues within acidic regions of proteins. The encoded protein is a type II integral membrane protein found in the Golgi body. Two transcript variants encoding the same protein have been found for this gene. |
|
Applications: |
ELISA, IHC |
|
Name of antibody: |
TPST2 |
|
Immunogen: |
Synthetic peptide of human TPST2 |
|
Full name: |
tyrosylprotein sulfotransferase 2 |
|
Synonyms: |
TANGO13B |
|
SwissProt: |
O60704 |
|
ELISA Recommended dilution: |
2000-5000 |
|
IHC positive control: |
Human esophagus cancer and Human breast cancer |
|
IHC Recommend dilution: |
25-100 |

 購物車
購物車 幫助
幫助
 021-54845833/15800441009
021-54845833/15800441009